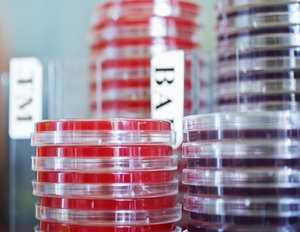

CDC collects, analyzes, and disseminates national surveillance data on bacterial foodborne illnesses in order to provide a national snapshot of the occurrence of infections transmitted commonly through food. Our goal is to decrease the burden of acute bacterial enteric illnesses in the United States. Experts in enteric diseases epidemiology and laboratory testing and analysis lead this effort.
Spotlight
Recently Posted Surveillance Reports
National Shigella Surveillance Annual Report and Appendices, 2013 [PDF – 18 pages]
National Typhoid and Paratyphoid Fever Annual Summary, 2014 [PDF – 8 pages]
National Salmonella Surveillance Annual Report and Appendices, 2013 [PDF – 89 pages]
National Cholera and Vibriosis Annual Summary, 2014 [PDF – 11 pages]
Listeria Annual Summary, 2014 [8 pages]
2014 CSTE Botulism Surveillance Summary [5 pages]
National Shigella Surveillance Annual Report, 2012 [ 9 pages]
Get Email Updates
To receive email updates about this page, enter your email address:
- Page last reviewed: July 17, 2015
- Page last updated: March 7, 2017
- Content source:
ShareCompartir